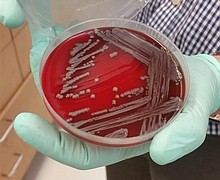

Children’s Museum of Houston Expands Beyond the Limits of Your Imagination During Sci-Fi Summer
The Children’s Museum of Houston’s “Sci-Fi Summer” will take you to infinity and beyond! From Memorial Day weekend through Labor Day weekend, you’re invited to take off on an out-of-this world adventure where imagination and reality collide. Come and explore …
May 15 Declared Earnest Pugh Day in Houston; Concept Video for "I Need You To Breathe" Released Today!
Coming off of the heels of a lavish red carpet affair attended by luminaries including the Mayor of Houston, Earnest Pugh announces the release of the “I Need You to Breathe” concept video. The resplendent clip was directed by Keith …
Chance the Rapper Poses with Musical Scores T-shirt
Chance the Rapper and the winning T-shirt design for The Pavilion’s Musical Scores program
Houston Area Urban League 49TH Annual Equal Opportunity Day Gala
The Houston Area Urban League (HAUL) will celebrate 49 years of providing services to the Greater Houston community on Saturday, June 17th, 2017 with its Equal Opportunity Day Gala featuring a dinner, Honoree recognition and entertainment. The event will be …
Parents, Alumni Push HISD Board To Revisit HSPVA Naming Rights
Ever since the Houston school board approved the naming rights to its flagship arts high school last fall, a vocal group of parents and alumni have opposed the deal. It let the Kinder Foundation add its name to the High …
Houston Had This Superbug Problem for Years and Never Knew
A dangerous strain of antibiotic-resistant bacteria is far more common in Houston than anyone knew and shows signs it can spread prolifically, researchers reported Tuesday. It's a specific strain of a bacteria known as Klebsiella pneumoniae.
Meet the Class of 2017: Tomorrow’s Future Leaders of America
After twelve years, 108 months, 3,240 days, are the estimated number of days students attend school before reaching the pinnacle of their educational career, high school graduation. That pivotal time has come for the class of 2017. It’s time for …
Senator Miles Advances Legislation to Address Food Insecurity and Repeal Predatory Traffic Program
"Food insecurity is a major issue affecting Senate District 13, that is why I proposed and passed SB 725 out of the Senate," said Senator Miles. "This bill would allow school districts to donate surplus food to nonprofit organizations and …
Manvel Native Serves at Sea Aboard Navy’s Largest Warship
A Manvel, Texas native and William P. Clements High School graduate, Petty Officer 3rd Class Rosembelt Villanueva is serving on one of the world’s largest warships, the U.S. Navy aircraft carrier USS Dwight D. Eisenhower (CVN 69).
Houston Host Memorable Celebration for Gospel Artist Earnest Pugh’s Top 20 Billboard Single "I Need You to Breathe"
It was an evening full of praise and worship for Dr. Earnest Pugh’s Billboard Celebration. Memphis native, Earnest Pugh, who recently moved to Houston, celebrated his eleventh Top 20 Billboard single, “I Need You to Breathe.”
Earnest Pugh's Billboard Celebration Hosted by Houston Mayor!
Monday, May 15, 2017, Mayor Sylvester Turner honored award-winning gospel singer, Dr. Earnest Pugh for reaching the top 10 on the billboard charts with his hit single, "I Need You To Breathe". The single marks Dr. Pugh's 11th billboard chart …
Russell Simmons Supports National Robotics Competition in Houston
Houston based, C-STEM Teacher and Student Support Services (C-STEM), a leading national nonprofit, exposing low-income children of color to the science, technology, engineering and mathematics (STEM) fields, is hosting the National C-STEM Challenge. This free, family-friendly event will be held …
Texas Southern Celebrates Spring Commencement
Texas Southern University saluted 1,139 candidates for graduation during Spring Commencement exercises on May 13 in TSU’s H&PE Arena. Texas Southern conferred 21 doctorate, 201 master’s, 230 professional and 686 bachelor’s degrees. Joanna Ramos, valedictorian, graduated Summa Cum Laude with …
Houston Native Serves at Sea Aboard Navy’s Largest Warship
A Houston native and Pairland High School graduate, Seaman Angel Evans is serving on one of the world’s largest warships, the U.S. Navy aircraft carrier USS Dwight D. Eisenhower (CVN 69).
Houston Native Selected as Senior Sailor of the Quarter
A Houston Community College and American Military University graduate with a Bachelor of Science degree, was selected as Senior Sailor of the Quarter for his outstanding work and dedication serving with Navy Medicine Professional Development Center (NMPDC) located in Bethesda, …